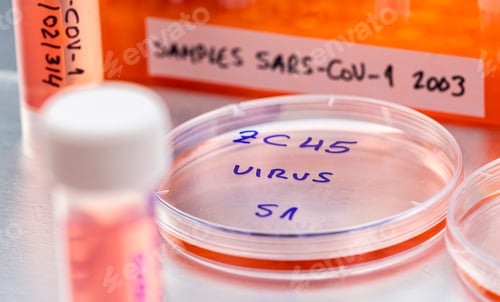
Preview: Close Up of Virus Sample in Petri Dish

Description
This striking abstract image features clusters of textured orange spheres scattered across a vibrant blue background. The spheres vary in size and density, some appearing as hollow rings while others are solid and dense. The composition is punctuated with smaller red and green dots, adding to the complexity and depth of the scene. The image evokes a sense of cellular biology or cosmic phenomena, suitable for projects related to science, technology, abstract art, or conceptual design. The dramatic colors and intricate details make this image visually compelling.